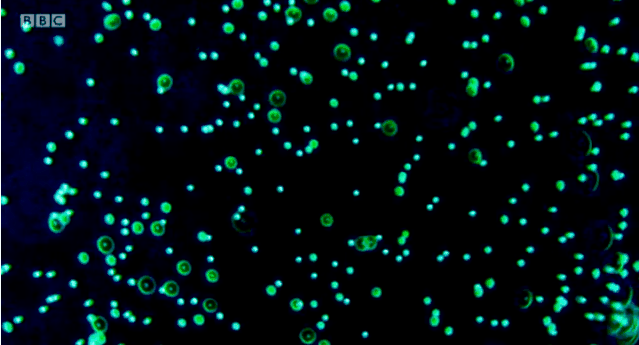

宝贝们大家好呀!今天有没有乖乖宅在家里呀?不要觉得太无聊,趁着这段时间,大家也可以来充充电。羊这就来拯救看手机快看吐了的
欢迎来到#跟着迷死氧看世界#栏目。 这次我们要去的地方是:水下。

认真的!地球上70%的地方都是海洋,大家有没有想象过,在这些水的深处究竟有什么?

2001年,BBC曾耗费五年时间,造访全球两百多个地方,拍摄了一部经典纪录片:《蓝色星球》。很多人对于海洋认知的启蒙都是起源于这里。

2017年,BBC时隔十六年之后,携《蓝色星球2》重磅归来。
从大家熟悉的海岸到黑暗的海洋深处,摄制组在水下拍摄长达6000多个小时,带来了更多前所未见的震撼景象。

而我们也首次如此真切地感受到了深海生物的智慧。

这些无一不在向我们揭示着水下世界的奇妙,也象征着人类对大自然奥秘的探索,从未停止。
不过今天,羊重点想跟大家说的,并不是《蓝色星球》,而是一部堪称中国版《蓝色星球》的片子——《水下中国》。
神奇的“水下中国”
如果说中国还有荒野,那一定是在水下。
这是我国第一部大型水下生态系列纪录片,也是第一部从水下展现中国的纪录片。为我们揭秘了中国近300万平方公里的海域下,那个奇妙的、未知的、且无可替代的世界。

跟随着《水下中国》我们看到,这里不仅有美妙绝伦的海底秘密花园。


还有古老神秘的水下古城、百年沉船。
一共是六集的纪录片,大概可以分为两个主题:自然与人文。
1. 神秘的水下世界
纪录片的第一集,摄制组把镜头对准了在水底幽深的黑暗洞穴。
还记得小时候学过的地理知识么?在中国南方有一种奇特的地质景观,叫做喀斯特地貌。而在喀斯特地貌的地下,同样有很高的研究价值。
奇特的钟乳石、独特的洞穴,是喀斯特地貌水下别具一格的自然奇观。

但在此之前,中国大部分的洞穴都未经探索和发掘过。原因很明显——地貌奇形怪状,洞穴阴暗幽深,实在是在危险了。
摄制组在广西都安瑶族自治县,找到了代表性洞穴,探索这里的生态系统。拍到了世界罕见、绝美的洞壁石花。

在幽深黑暗见不着光的洞穴里,还附着很多未知的生物,也都是生命的奇迹。

比如盲虾。这是一种特别稀有的、对生存环境要求极高的生物,大多生存在洞穴最底层,因为这里的水质最为纯净。
在此之前,国内还从来没有人真正拍到过它。

盲虾虽然眼睛看不见,但是有特别敏感的皮肤触觉,可以帮助他们在曲折的洞穴和洞壁上攀岩,从不撞墙。

《水下中国》还为我们揭秘了五彩斑斓的海底秘密花园。在这座秘密花园里,有一个非常重要的组成成员——珊瑚。
珊瑚可以分为造礁珊瑚和非造礁珊瑚,这些珊瑚有的会发出荧光,有的软乎乎的像气球、像泡泡。


而大家能想象珊瑚是如何繁衍的吗?下面是纪录片拍到的珊瑚排卵的瞬间。

月光照耀下,珊瑚丛释放出无数颗微小的卵子,像满天繁星,点亮了生命的烟火。

漂浮的卵子会跟同样漂浮在海水里的精子相遇,两者结合组成水螅体,再慢慢发育、长大成为珊瑚虫。


由造礁珊瑚所构筑成的珊瑚礁,也是一个生态系统,和各种海洋生物相爱相杀,热热闹闹地“生活”着。


物竞天择,珊瑚的生存也会受到挑战,被其他的生物啃食和吞噬。

但这都不算什么,最大的威胁,来自人类的环境污染,以及自然气候的变化。
镜头还记录下了这样的画面:全球气候变暖,珊瑚虫死亡还引起了大规模珊瑚白化现象,提醒我们所有的美丽,如果没有尊重和保护,都终会逝去。

2. 古老的水下文化
不过羊更感兴趣的,还是那些从水下看到的中国文化。
如果说《蓝色星球》是世界的,那么《水下中国》就是中国唯一的——纪录片导演周芳这么说道。
中国有着古老而漫长的历史。从古至今就是一个盛产故事的国家,连水下的故事,也不例外。水下古城,听起来就很带感。在浙江千岛湖的湖底,就有一座被淹没的古城,叫做狮城。是原来遂安县的县城。
上个世纪五十年代,新安江水电站拦坝蓄水,湖水淹没了县城、村庄,这座有着将近2000年历史的古城,从此淹没在碧波之下。

老移民章应贤,原本是遂安县人,用了十年的时间,走访四散在各处的移民,完成了一幅《狮城原貌图》。

而《水下中国》则将他们朝思暮想的故乡,通过视觉直接呈现。

城北门的节孝坊,距今300多年,是中国水下唯一一座保存完好的砖墙结构牌坊。

牌坊上的精雕细刻都被完全保留。龙、凤,狮子滚绣球,精美而耐人寻味。


而水下的民宅,则更有生活气息,从门头的牌匾,精美的廊檐,似乎都能看到这里有人曾用心生活过的痕迹。
经过当事人允许,摄制组专门去探索拍摄了一户完整的许家大院:余庆堂。

门头牌匾上刻着“山屏水带”四个大字。

房梁的雕花依然精细可见。

院子里残留着砖垒的曾经做饭的灶台。

屋后的楼梯上,堆满了后来居上的乱石。许家老人说,自己的父亲曾经在这里用酒坛子当武器,保护过这个家。

拍摄前,许老曾央求摄制组帮忙带一片自己老家的瓦片上来。周芳在水下拿起来之后,几十年沉淀的灰尘被水流一冲而散。她不想破坏房屋原本的样子,将瓦片又放了回去。
探索的本质是了解,而方式,是尊重。除了水下古城之外,《水下中国》还拍到了抚仙湖湖下的水下金字塔。

河北潘家口的水下长城。
还有一集主题是:海下沉船。
三十多年前,一艘韩国出使的远洋巨轮,沉浸在中国台湾兰屿岛附近的海水深度。三十多年后,这里变成了一片生机盎然的海礁,长满了海扇、珊瑚。

鱼群游过沉船,这艘巨轮也在水底获得了新生。

《水下中国》的背后
这样的一部纪录片,背后的摄制团队仅仅只有六人,其中有两名女生。导演周芳就是其中之一。

周芳是一个有着极大生命热情的湖南妹子,最早的时候,她只是一名普通的大学生。
一次偶然的度假,她在澳洲见识到了美丽的海底世界,从此像打开了一扇新世界的大门,爱上了潜水。

在世界各地的海底潜水探险时,有一次跟外国人交谈起自己的国家,她猛然发现潜水这么多年,竟然对中国水下毫不了解。于是她下定决心,要拍一部记录下中国水下世界的纪录片。

周芳始终都记得她的初衷:一个中国人对自己脚下土地的一种渴望,一种本能,一次冲动。但这显然并不是一个很容易的挑战。
中国之所以之前没有这样的片子,一是因为关注的人确实太少了,另一个原因,就是太难太危险了。

水下艰难的拍摄条件、随时面临的危险,也更衬托出这些水下画面的珍贵。在每一集纪录片的片尾,导演周芳都会讲述一些拍摄时的幕后花絮。
比如拍摄第一集“黑暗洞穴”时,由于水下几乎没有光线,而且洞穴的结构也非常复杂,一旦在水下走错方向、跟同伴走失,就会有被困水底的风险。

所以洞穴拍摄,需要有非常娴熟的潜水技能以及足够过硬的心理素质。

周芳和同伴在拍摄中就遇到过这样的险境。
有一次为了把一只盲虾拍清楚,她和另一个女队友跟随着盲虾游进了一个侧洞。结果偏离了引导绳,进入到了洞穴盲区。
因为没人进去过,稍微一动就激起了大量尘土和泥沙,成为了一个全黑暗的空间。
“就像被困在棺材里,只能听到自己的呼吸声”。

那一刻,周芳感受到了死亡的逼近,什么想法都有了。但还是要强迫自己冷静下来,去摸索着寻找出口。
幸运地是,她们摸到一个死胡同,于是折回往相反的方向游,终于找到了出口。
这样的险况在长达三年的拍摄周期中并不罕见。
拍摄水下古城时,由于好多民宅都是木质结构,在水下六十多年,已经变得腐朽、脆弱,一不小心就有坍塌的风险。所以在下水前,要对每一座建筑结构有足够的了解。

但所有的这些危险和不易,在她看到中国水下那美丽绝伦的世界时,在看到水下的新生命破卵而出时,在帮助那些老人找回儿时记忆、重拾温暖时,全都变得微不足道了。
《水下中国》,看到的是画面,而记录下来的是人类最本真的情感。
就像导演周芳说的:《水下中国》不是奇迹,只是人和水下的对话,是一次次触及灵魂的感动。

最终这部纪录片为了庆祝祖国70岁的生日,在去年9月底播出。
可惜的是,这样一部纪录片,目前知道的人却并不多。甚至因为看过的人太少,在豆瓣上都还没有打分。 但是看过的其中,不乏这样四五分的高分好评。


当然,或许也有人看过后有不同的想法,认为比不上《蓝色星球》,认为画面没有足够美,但是羊觉得,有勇气去尝试,有毅力克服重重困难完整地拍下来,这样的努力就值得被大家看见了。
只有被看见了,才会越来越好。